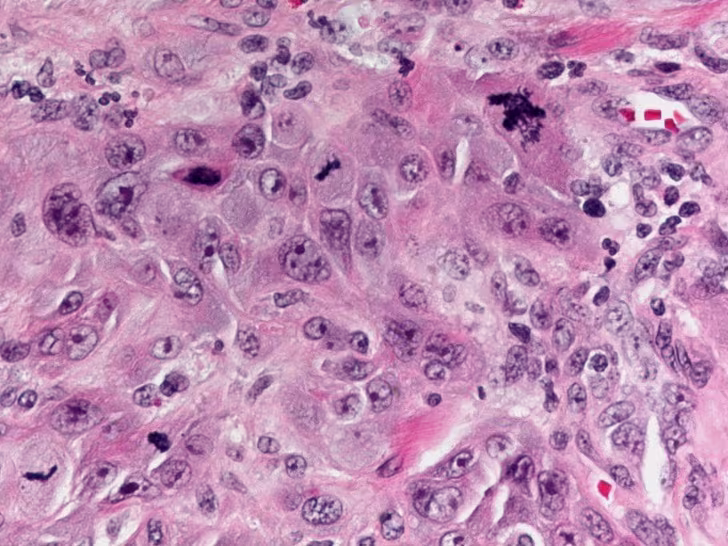

Incidental Keratosis with Ulceration Noted in Patient with Oral Lichen Planus
Case Challenge Number: 63
Diagnostic Information
History of Present Illness Ms. Fernandez is an 82-year-old Argentinian female who presents for her routine 6 month check-up. She relates no specific complaints. She has been successfully using a topical steroid rinse (dexamethasone 0.5g / 5mL) 2-3 times per day as needed to control her oral lichen planus, which was diagnosed 5 years ago. A review of her medical history reveals: Medical History - Adverse drug effects: none
- Medications: Tramadol/APAP, Lovastatin, benazepril, Bayer ASA, Caltrate
- Pertinent medical history: hypertension; hypercholesterolemia; osteoarthritis with chronic back pain
- Pertinent family history: paternal - died age 98 of “old age”; maternal - diabetes type 2, breast cancer, died at 62 from a myocardial infarction; no siblings
- Social history: pt. denies any smoking, no ETOH, no recreational drug use Clinical Findings Extraoral examination: (+) crepitus on left TMJ, no limitations or pain on opening, no lymphadenopathy. Intraoral examination: an irregular-shaped area of thick keratosis surrounding a granular appearing erosion is present on the lower left alveolar ridge in the area of #17 (Figure 1). Gentle palpation of this area provokes sponateous bleeding with no discomfort. A panorex is ordered and reveals non-restorable #2 and #3 and a supererupted #15, but no obvious osseous pathoses affecting the lower mandibular region (Figure 2). An incisional biopsy is performed in the lower left alveolar ridge area and the tissue is submitted for histopathologic examination.
Figure 1. Asymptomatic, granular ulceration with associated keratosis.
Figure 2. Panorex reveals supererupted and carious #s 2, 3, and 15 and no obvious osseous pathosis on mandible.
Histopathologic Findings The histologic sections of the incisional biopsy show infiltrating cords and islands of atypical squamous epithelium arising from dysplastic surface mucosa. There is a supporting fibrovascular connective tissue stroma with lymphocytic interface chronic inflammatory infiltrate. The epithelial cells displays pleomorphic round to oval nuclei with finely dispersed to vesicular chromatin, prominent nucleoli, increased nuclear to cytoplasmic ratio and pink focally dyskeratotic cytoplasm. There are numerous abnormal mitotic figures and focal single apoptotic cells.
Figure 3. Low power histologic image showing invasive cords and islands of squamous epithelium extending into chronically a inflamed fibrovascular connective tissue stroma. The surface mucosa is dysplastic and parakeratotic.
Figure 4. High power histologic image showing atypical epithelial cells with pleomorphic round to oval nuclei, finely dispersed to vesicular chromatin, prominent nucleoli, increased nuclear to cytoplasmic ratio, and pink focally dyskeratotic cytoplasm. There are interspersed abnormal mitotic figures and single apoptotic cells.